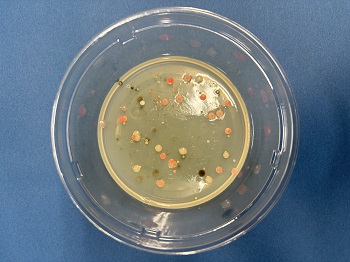
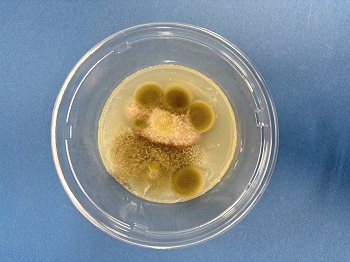
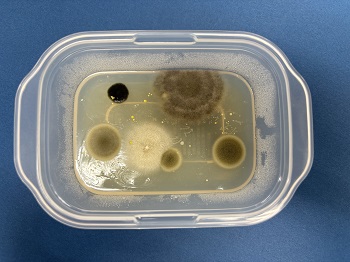
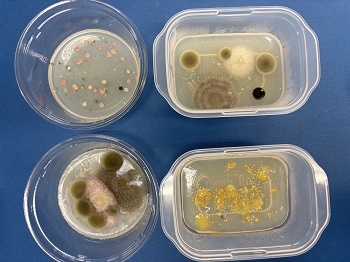

2026.03.19
2026.03.19
自転車小屋の建て替え 11月4日(火)
・老朽化に伴い、自転車小屋を解体しています。建て替えまでの工事期間は約1ケ月間を予定しています。※解体作業中の自転車小屋

※臨時駐輪場は、グラウンド庭園前に。

※下校する生徒たち。

※雨の日は玄関に備え付けのサドル拭き用タオルをどうぞ!

全校朝会 11月4日(火)
・11月に入り、空は快晴ながらも、朝の空気はすっかり冬の気配を感じさせる冷たさでした。本日の全校朝会では、校長先生から11月の学校生活についてのお話がありました。期末テストに向けた「学習強調週間」が始まり、生徒たちは日々の授業や自主学習に一層力を入れていること。また、委員会が中心となって企画・運営する「球技大会」や、ウノ・オセロを使った「中・中No1決定戦」など、放課後の活動計画も進んでいることが紹介されました。こうした学びと活動の両面で、生徒一人ひとりが自分の力を発揮し、仲間と協力しながら学校生活をさらに充実させていくと話されました。


学習強調週間 11月4日(火)
・テスト1週間前になりました。今日から放課後質問教室が始まり、教室では先生に質問したり、仲間と教え合ったりする姿が見られました。※集中して取り組む生徒たち。学びへの意欲が感じられます!



エコキャップ 11月4日(火)
・保健給食委員会の生徒たちが、JA新潟かがやき中野小屋支店様を訪問し、これまでに集めたペットボトルのフタを届けました。委員会の生徒たちは合計16.3kgのフタを集め、環境活動と社会貢献の両面から取り組みを進めています!
・この活動は「エコキャップ運動」と呼ばれ、ペットボトルのフタを回収・リサイクルすることで、CO₂の削減や資源の有効活用につながるだけでなく、発展途上国の子どもたちへのワクチン支援にも役立てられています。
※秋晴れの空のもと、中学校からJAまで歩いて行きました。

・今回の活動には、地域の皆様からも多くのキャップの持ち込みもご協力いただきました。学校と地域が一体となって取り組むことで、より大きな力となり、温かいつながりを感じることができました。
・生徒たちは、こうした身近な行動が世界につながっていることを、今回の活動を通して実際に感じ取ることができました。自分たちの手で集めたキャップが、遠く離れた国の子どもたちの命を守るワクチン支援につながることを知り、活動の意義を改めて実感していました。

あなたの姿勢、大丈夫? 11月4日(火)
・「最近、姿勢が気になる…」そんなあなたにおすすめの簡単チェック方法があります!
・場所は保健室前の掲示板。そこに立って、目を閉じたまま足踏みを50回してみましょう。終わったら目を開けて、最初の位置からどれだけ移動しているかを確認してみてください。



・移動した方向や距離から、体のゆがみや普段の姿勢の様子が見えてきます。実は、姿勢の乱れは見た目だけでなく、視力の低下や歯並びのバランス、腰痛・頭痛などの体調不良にもつながることがあります。日々の生活の中で気づきにくい体のサインを、ぜひこの機会にチェックしてみましょう。気になる人は、保健室前でチェック!
後期中間テスト 11月11日(火)
・定期テストもいよいよ後半戦に突入しました。前期で得た工夫や習慣がどれだけ自分の成長につながっているかを振り返るチャンス。自分に合った学び方を続けることで、少しずつ積み重ねてきた努力が形になる瞬間を楽しみにしています。


生徒朝会 11月18日(火)
・最初に、選挙管理委員の紹介がありました。実行委員長からは、立候補の人たちのために委員長として選挙活動が滞りなく活動ができるように努めていきたいと思います。
※選挙管理委員一人ひとりから意気込みを語ってくれました。

※現生徒会三役からそれぞれの役職の立場から仕事内容、やりがいについて1年間務めた経験から話をしてくれました。

食育教室(2年生) 11月18日(火)
・給食センターから栄養士のかたをお招きし、食育教室を実施しました。食事の基本は主食、主菜、副菜、汁物です。この4つのバランスを考えながらメニューを考えてみましょう。とお話がありました。
※どんなメニューがみんなにとって理想的な昼食になりそうですか?

※過去のメニューを見ながら、自分なりに栄養バランス、彩を考慮して理想のメニューを考えました。

柔道教室 11月18日(火)
・柔道で大切なことの一つである「礼」について、正しい立ち方、お辞儀の仕方などを皆で丁寧に復習しました。柔道着の着方や畳への上がり方といった基本動作にも真剣に取り組みます。

「礼」の復習を終えた後は、準備運動、そして受け身の練習からスタートしました。そして、いよいよ背負い投げの体さばきの練習です!

専門委員会 11月18日(火)
・定例の委員会です!先月からの活動を振り返りました。※生徒会本部では、今年度のスローガンを評価するためのアンケートについて、どのように意見を吸い上げるかをテーマに話し合いました。多くの人の声を反映できるよう、委員たちが工夫を凝らしながらアイディアを出し合っていました。

※学級委員会:募金活動の打ち合わせ

※激励生活委員会:球技大会の打ち合わせ。大詰めです!

※図書広報委員会:12月の企画打ち合わせ

※保健給食委員会:「衛生実験中」ロッカー、髪の毛、引き戸など人の手が触れそうなところをさわっています!



※保健給食委員会では、日常生活の中で人の手が触れる場所に、どれほどの汚れが付着しているのかを課題に、調査や実験活動を行いました。結果の発表は数日後を予定しています。どうぞお楽しみに!
柔道1年生 11月19日(水)
・1年生が初めての柔道に挑戦しました。柔道着の着方や帯の結び方といった基本から練習を始め、慣れない動きにも一生懸命取り組んでいました。
進学説明会 11月21日(金)
・令和8年度の入試に向けて、PTA3学年委員会が司会進行となり、2、3年生と3年生の保護者の皆さんを対象に入試手続きについて説明会がありました。
※入試の状況が昨年度と異なる点がいくつかあり、これから入試準備を進める際に気をつけたいことや、各高校で必要となる手続きについて説明がありました。

調理実習(3年生) 11月25日(火)
・今回のテーマは「幼児のおやつ」。家庭でも手軽に楽しめるホットケーキをメインにメニューを考えてみました。 焼きたてのホットケーキはそれだけでも十分美味しいですが、ちょっとした工夫で彩りを添えることができます。例えば、リンゴやバナナなどの果物を一緒に盛り付けると、ふんわりとした生地にシャキッとした食感が加わり、甘さのバリエーションも広がります。見た目も華やかになり、シンプルなおやつが食後のデザートに早変わり!ほんの少しの工夫で、いつものホットケーキが特別な一皿に変わりました。※後片付けの手際も素晴らしい!

評議委員会 11月26日(水)
・今週末に予定していた球技大会について、激励生活委員会より「延期」の提案がありました。 理由は、インフルエンザによる感染者が増えてきているため。生徒の健康を第一に考え、また楽しみにしていた大会をより良い形で実施するため、評議委員の一致した意見で延期は決定しました。皆で意見を出し合い、同じ思いを共有しながら決定できたことは、とても意義のあることだと感じました。
保健給食委員会の手洗い実験 11月28日(金)
・11月18日(金)の委員会活動で、「手洗いと菌の関係」について実験を行いました。結果を写真付きでご紹介します。 ※カビのふわふわした様子が苦手な方は閲覧注意です!【実験結果】
◆11月18日(金)培地の初期状態
※培地(ばいち):菌を育てるための栄養が入ったゼリーのもの。手についている菌がここで増えることで、目に見える「コロニー」として観察できます。

◆その1:石鹸で丁寧に洗った手
・コロニー(菌の集まり)が確認されました。
・手には常在菌が存在し、すべてが「悪い菌」というわけではありません。これが基本の状態です。
◆その2:「その1」の手で髪の毛をさわり、着衣で拭いた手
・「その1」と比べると、見慣れないコロニーが急増しています!
◆その3:水だけで洗った手
・「その1」に近い状態ですが、細かいコロニーが多数見られました。

◆その4:手洗いをしていないそのままの手
・「その2」の結果と似たような黒っぽいコロニーが確認されました。これは常在菌だけでなく、学校生活の中で触れるバスケットボールやロッカー、教室の出入口の戸などから付着した菌の可能性が高いと考えられます。普段何気なく触れているものを通じて、手には多様な菌が付着していることがわかりました。
【まとめ】
・手を洗っても、他のものに触れるだけで菌が付着することが分かりました。しかし、石けんで洗うことで衛生的な状態を作り出せることも確認できました。
・今回の実験を通して、委員会の生徒たちは「手洗いの大切さ」を自分たちの目で確かめることができました。写真を見ながら一生懸命まとめていた姿に、とても頼もしさを感じました。実験結果を活動の成果として活かし、「正しい手洗い」を呼びかける企画につなげていけるのは素晴らしいことです。委員会のみなさん、見事です!
※12月1日(月)保健室前掲示板の様子












